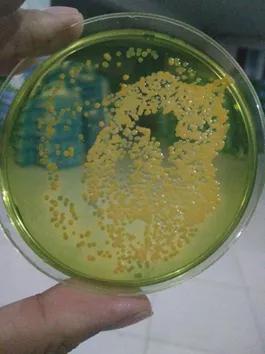
对虾黄鳃黑鳃是什么原因,对虾黄鳃防治

腾氏水产商务网独家报道:
作者 | 湖北至正天辰生物科技有限公司 马良骁
高温南美白对虾养殖问题突出,特别是像今年华南连续的高温少雨天气,导致对虾鳃部问题也越来越多,鳃挂脏、绿鳃、鳃水肿、黄鳃、黑鳃甚至烂鳃等,但很多养殖朋友却忽视了对虾的鳃部问题,鳃是对虾的呼吸器官,主要靠鳃来呼吸,由于对虾鳃部问题,对虾缺氧、浮头,连续几天缺氧浮头之后,出现大批量死虾,这说明了对虾鳃部的重要性。另对虾鳃部也是除肠道、甲壳之外的一个“吸收”器官,每天对虾鳃部要过滤成千上万遍的水,特别是我们施到水体中的很多营养物质,都是通过鳃进入的消化道,鳃的重要性不言而喻,如若处理不好,同样会引起很严重的后果,笔者根据近段时间一线实践服务,对最近出现较多、又让人心“鳃”的对虾黄黑鳃问题,进行总结分享,希望对广大养虾朋友有所帮助。
一、对虾黄黑鳃发生原因
1)气候原因,死亡藻类、有机质附着
连续的高温、少雨、闷热天气,本身就容易发生对虾黄黑鳃,加之高温藻类新陈代谢快,老化快,死藻代谢不了,悬浮死藻、水体悬浮有机质,导致鳃丝挂脏,刺激鳃部,鳃丝张开,分泌粘液,引起鳃丝发炎,就容易出现对虾黄黑鳃,甚至鳃水肿现象;


2)藻类多引起的水浓,藻类直接堵住鳃丝,时间一久,长期不处理,堵塞鳃部,就易导致对虾黄黑鳃出现;


3)底质原因,死藻、水体悬浮有机质沉积池底,底部净化不够,导致底部有机污物增多,底部恶化严重,易导致对虾黄黑鳃;
4)水质氨氮、亚盐超标,特别是氨氮偏高,高氨氮浓度会刺激对虾鳃部,影响对虾呼吸与排泄,易出现对虾黄黑鳃,且多发现下午虾跳;


5)纤毛虫寄生
一般纤毛虫镜检时,多镜检对虾腿、尾扇,也是因为纤毛虫多寄生在这几个部位,但由于纤毛虫寄生过多,对虾活力、体质下降,镜检鳃部时也发现鳃丝寄生大量的纤毛虫,而且已影响对虾呼吸,造成对虾游塘、缺氧、浮头等,多表现为对虾黄鳃;


6)弧菌感染
高温,没有定期改底、消毒,没有针对性改底的池塘,有机质、死藻多成了弧菌生长的“温床”,容易携带弧菌粘附鳃丝,实际弧菌检测也发现对虾黄黑鳃的鳃部弧菌明显高于健康虾的,弧菌感染多表现为对虾黑鳃、甲壳溃疡;

7)环境性黑鳃,特别是像模式比较低端的土塘鱼虾混养模式,还在使用硫酸铜、高锰酸钾等制剂的,易出现此种现象。
二、对虾黄黑鳃的危害


1)堵塞鳃部,影响呼吸,导致游塘、趴边、缺氧、浮头;
2)导致虾体瘦弱、棉花虾,寄生纤毛虫,感染弧菌;
3)慢料、不蜕壳、慢大,特别是轮捕模式抓虾不进笼,进笼体质差,规格上不来;
4)偷死、排塘;
5)卖相差,虾贩压价,少卖钱。
三、对虾黄黑鳃的防控
鳃主肝,肝主肠,肠主肉壳,也看出了鳃的关联性很大,不处理好鳃病,危害很大,且易引起一系列问题,所以说又有“治病先治鳃”之说,而对虾黄黑鳃重点在预防,预防的重中之重又在于底质的改善和水质的调控。
3.1 如何防控?
1)高温水挥发快,有条件的可换水、加水,保持一定的高水位;
2)高温死藻、悬浮物多,多解毒、调水,可使用富含表面活性剂含量较高的清洁泡泡酸,配合粪链球菌调水,不耗氧,高温替代芽孢杆菌,分解有机质,保持水体通透性;
3)高温池底有机污物多,要定期改底,交叉改底,针对性改底,可使用光催化型底改、高铁酸盐类底改、富含粪肠球菌、硫化氢氧化细菌的不耗氧生物底改,交叉改底,氧化、分解底部有机质,同时缓解底热,预防黄黑鳃。
4)科学投喂,减少残饵、粪便等有机污物,定期使用活菌调水分解有机质,定期使用水体平衡调节剂,给藻类、菌类、水体动力,延迟水体稳定的时间,一定程度上控制氨氮、亚盐。
3.2 如何处理?
对虾鳃病严重的,既要消炎更要改底、调水:
1)使用季铵盐类底改,建议傍晚时候使用,虾更不容易缺氧,水质浓的下重些,水质瘦的下轻些,虾大的下重些,虾小的下轻些,清洁鳃部;
2)配合使用抗菌药(如氟苯尼考)+大黄内服,消除鳃部炎症;
3)配合加水,效果更好;
4)处理期间,一定要控料、减料甚至停料。
转载声明
本文为当代水产-腾氏水产商务网独家原创稿件,未经授权,一律禁止转载!